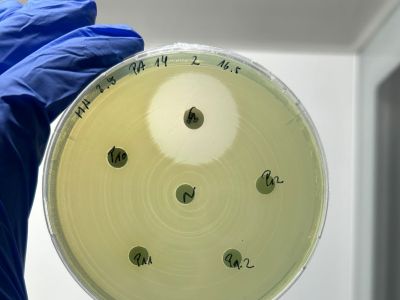
hemmtest---agarplatte-mit-testplattchen-400x300

MIKROAKTIV PROJEKT
Stärkung der Sicherheit, Nachhaltigkeit & Funktionalität von Lebens- und Futtermitteln

Team
Foto: FH OÖ
Hemmtest - Agarplatte mit Testplättchen
Foto: Julia Kirchsteiger

Verschiedene Agarplatten mit Pflanzen
Foto: Julia Kirchsteiger
MikroAktiv ist ein Kooperationsprojekt zwischen der FH Oberösterreich und dem Austrian Competence Centre for Feed and Food Quality, Safety & Innovation (FFoQSI) am Forschungsstandort Wels. Das Projekt fokussiert die Interaktion zwischen Mikroorganismen mit Nahrungs- und Futtermitteln, mit dem Ziel, die Sicherheit, Nachhaltigkeit und Funktionalität zu erhöhen.
Mikroorganismen haben einen bedeutenden Einfluss auf die Qualität von Nahrungs- und Futtermitteln. Sie können entlang der gesamten Wertschöpfungskette zu Kontaminationen führen, sowie durch ihre Stoffwechselprodukte auch den gesundheitlichen Nutzen von Nahrungs- und Futtermitteln für Mensch und Nutztier erhöhen. Umgekehrt können Nahrungsmittel und natürliche pflanzliche Wirkstoffe auch protektiv gegen pathogene Mikroorganismen wirken.
Projektziele und erwartete Ergebnisse
Das Projektziel liegt in der Erforschung, Entwicklung und Implementierung neuer Technologien und ausgewählter wissenschaftlicher Ansätze zur Verbesserung und optimierten Nutzung von Nahrungs- und Futtermitteln.
- Konkret sollen neue natürliche Wirkstoffe mit antimikrobiellen Eigenschaften - als natürliche Alternative zu Antibiotika - auf Basis unterschiedlicher Extraktbibliotheken, insbesondere aus regionalen Rohstoffen, identifiziert werden.
- Zudem sollen pflanzliche Rohstoffe und deren Inhaltsstoffe durch Biotransformation verändert werden, sodass eine potentiell gesundheitsfördernde Wirkung erreicht werden kann. Mikroorganismen können durch Fermentation pflanzliche Inhaltsstoffe umsetzen und deren biologische Aktivität erhöhen.
Leistungszeitraum
Projektbeginn: 01.01.2024 / Projektende: 31.12.2028 / rund 2 Mio. Projektbudget
Nähere Informationen zum Programm IBW/EFRE- & JTF finden Sie auf www.efre.gv.at.

Lead Researcher: 
FH-Prof. Priv.-Doz. Dr. Julian Weghuber
FFoQSI Area Leader GREEN
Leiter CoE Lebensmitteltechnologie und Ernährung
Lebensmitteltechnologie und Ernährung an der FH Oberösterreich
julian.weghuber@fh-wels.at
+43 5 0804 44403
www.fh-ooe.at
Project Leader:

Dr. Bettina Schwarzinger
MikroAktiv Projektkoordinatorin & Senior Researcher
bettina.schwarzinger@ffoqsi.at
+43 5 0804 44170
www.ffoqsi.at
www.fh-ooe.at